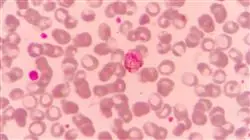
##IMAGE##

Universitäre Qualifikation
Die größte Fakultät für Medizin der Welt"
Präsentation
Sie werden sich der Herausforderung der Reisemedizin in der ärztlichen Praxis stellen, unter dem Gesichtspunkt der internationalen Gesundheit und zusammen mit den heutigen Experten auf diesem Gebiet"

Bei Tropenkrankheiten handelt es sich um Infektionen, die vor allem in Regionen mit warmem und feuchtem Klima auftreten, die häufig wirtschaftlich, sozial und gesundheitlich in der Entwicklung sind. Ihre Diagnose nach der Einfuhr ist der Schlüssel, um ihre Ausbreitung zu verhindern. Daher ist es wichtig, den Bestimmungsort zu prüfen, um die erforderlichen Impfungen zu erhalten, und nach der Rückkehr ins Herkunftsland eine Nachuntersuchung durchzuführen. Parasitäre Krankheiten, Viren und Infektionen sind in Klimazonen, die nicht an sie gewöhnt sind, in denen die Bevölkerung keine Immunität aufgebaut hat oder in denen die Lebensqualität anders ist, leicht übertragbar.
In ähnlicher Weise hat die globale Erwärmung dazu geführt, dass sich Moskitos, Zecken und andere Insekten, die Viren oder Bakterien übertragen, in den letzten zehn Jahren in ganz Europa vermehren, sich an unterschiedliche Jahreszeiten anpassen und neue Gebiete erobern konnten. Ausbrüche von Dengue-Fieber wurden in Frankreich und Kroatien, Malaria in Griechenland, West-Nil-Fieber in Südosteuropa und das Chikungunya-Virus in Italien und Frankreich gemeldet.
Das europäische Klima wiederum ist bereits für die Übertragung der Lyme-Krankheit und der durch Zecken übertragenen Enzephalitis geeignet (beide werden hauptsächlich durch Ixodes ricinus übertragen). In der EU treten jährlich durchschnittlich 65.000 Fälle von Lyme-Krankheit auf, und die Zahl der Enzephalitis-Fälle in den europäischen Endemiegebieten ist in den letzten 30 Jahren um 400% gestiegen (was teilweise auf eine verbesserte Überwachung und Diagnose zurückzuführen ist).
Daher ist eine Spezialisierung wie dieser universitätskurs in Reisemedizin und Internationale Gesundheit notwendig, um sich auf die Forschung und die Entwicklung von Maßnahmen zur Verhinderung von Ansteckungen zu konzentrieren. Die Teilnehmer an diesem Programm erwerben die Kenntnisse, Protokolle und Fähigkeiten, die für die Erkennung, Diagnose und Behandlung dieser Art von Krankheit nach einer internationalen Reise erforderlich sind.
Außerdem ist es ein 100%iger Online-Studiengang, der es den Studenten ermöglicht, bequem zu studieren, wo und wann sie wollen. Alles, was Sie brauchen, ist ein internetfähiges Gerät, um Ihre akademische Laufbahn einen Schritt weiter zu bringen. Eine zeitgemäße Modalität mit allen Garantien für die Positionierung des Fachmanns in einem boomenden Sektor.
Kombinieren Sie diesen Universitätskurs mit Ihrem persönlichen Leben! Dieses Programm ist zu 100 % online, Sie entscheiden, wo, wann und wie Sie es absolvieren wollen”
Dieser universitätskurs in Reisemedizin und Internationale Gesundheit enthält das vollständigste und aktuellste wissenschaftliche Programm auf dem Markt. Die hervorstechendsten Merkmale sind:
- Neueste Technologie in der E-Learning-Software
- Intensiv visuelles Lehrsystem, unterstützt durch grafische und schematische Inhalte, die leicht zu erfassen und zu verstehen sind
- Entwicklung von Fallstudien, die von aktiven Experten vorgestellt werden
- Hochmoderne interaktive Videosysteme
- Der Unterricht wird durch Telepraktika unterstützt
- Ständige Aktualisierung und Recycling-Systeme
- Selbstgesteuertes Lernen: Vollständige Kompatibilität mit anderen Berufen
- Praktische Übungen zur Selbstbeurteilung und Überprüfung des Gelernten
- Hilfsgruppen und Bildungssynergien: Fragen an den Experten, Diskussions- und Wissensforen
- Kommunikation mit der Lehrkraft und individuelle Reflexionsarbeit
- Verfügbarkeit von Inhalten von jedem festen oder tragbaren Gerät mit
- Internetanschluss
- Datenbanken mit ergänzenden Unterlagen, die auch nach dem Kurs ständig verfügbar sind
TECH bietet Ihnen einen Universitätskurs mit einem multidisziplinären Ansatz, der sich mit den häufigsten Pathologien von Patienten befasst, die von einer internationalen Reise zurückkehren"
Zu den Lehrkräften des Programms gehören Fachleute aus der Branche, die ihre Berufserfahrung in diese Fortbildung einbringen, sowie renommierte Fachleute von Referenzgesellschaften und angesehenen Universitäten.
Die multimedialen Inhalte, die mit den neuesten Bildungstechnologien entwickelt wurden, ermöglichen den Fachleuten ein situiertes und kontextbezogenes Lernen, d. h. eine simulierte Umgebung, die ein immersives Training ermöglicht, das auf reale Situationen ausgerichtet ist.
Das Konzept dieses Studiengangs konzentriert sich auf problemorientiertes Lernen, bei dem die Fachkräfte versuchen müssen, die verschiedenen Situationen aus der beruflichen Praxis zu lösen, die während des Universitätskurs Studiengangs gestellt werden. Dabei wird die Fachkraft durch ein innovatives interaktives Videosystem unterstützt, das von anerkannten Experten entwickelt wurde.
Sie werden die Vorbeugung, Diagnose und Behandlung von Tropenkrankheiten und die internationale Gesundheit mit Experten auf diesem Gebiet eingehend studieren"

Dank dieses Universitätskurses von TECH werden Sie in der Lage sein, eine sichere klinische Diagnose zu stellen, die durch den effizienten Einsatz von Diagnosemethoden unterstützt wird, um eine wirksame integrale Therapie anzugeben"
Ziele und Kompetenzen
Die Gestaltung dieses Universitätskurses wird es den Studenten ermöglichen, die notwendigen Fähigkeiten zu erwerben, um ihr Wissen im Bereich der internationalen Gesundheit und der Reisemedizin zu aktualisieren und zu vertiefen, von den Überlegungen vor der Reise bis zur Bewertung nach der Rückkehr. TECH stellt somit die Instrumente für die Fortbildung von Studenten in diesem medizinischen Bereich zur Verfügung, wobei der Schwerpunkt auf den Symptomen liegt, die bei Reisenden auftreten können, damit sie rechtzeitig diagnostiziert und richtig behandelt werden können, wobei der Schwerpunkt auf der Untersuchung liegt, um die Übertragung von Krankheiten zu verhindern. Auf diese Weise wird die Entwicklung des Lehrplans, der von den besten Fachleuten ausgearbeitet wurde, es den Studenten ermöglichen, die vorgeschlagenen Ziele zu erreichen und sie zu Spitzenleistungen in ihrem Beruf zu führen.
Sie werden lernen die Bedeutung von Morbidität und Mortalität aufgrund von Infektionen bei internationalen Reisenden hervorzuheben"
Allgemeines Ziel
- Gewährleistung einer professionellen Verbesserung durch die neuesten und aktuellsten wissenschaftlichen Erkenntnisse für die Vorbeugung, Diagnose und Behandlung von Tropenkrankheiten und internationaler Gesundheit mit einem multidisziplinären und integrierten Ansatz, der die Kontrolle dieser Pathologien erleichtert
Spezifische Ziele
- Ausbilden und Vertiefen der Theorie in der Praxis, um eine sichere klinische Diagnose zu ermöglichen, die durch den effizienten Einsatz von Diagnosemethoden unterstützt wird, um eine wirksame integrale Therapie anzuzeigen
- Hervorhebung der Bedeutung der Morbidität und Mortalität von Infektionen bei Auslandsreisenden
- Erläuterung der komplexen Zusammenhänge zwischen ätiologischen Erregern und Risikofaktoren für den Ausbruch dieser Krankheiten

Sie werden in der Lage sein, die komplexen Zusammenhänge zwischen ätiologischen Keimen und Risikofaktoren für den Erwerb dieser Krankheiten zu erklären"
Universitätskurs in Reisemedizin und Internationale Gesundheit
Entdecken Sie das faszinierende Gebiet der Reisemedizin und der internationalen Gesundheit mit dem Universitätskurs der TECH Technologischen Universität. Unsere Online-Kurse bieten Ihnen die Möglichkeit, sich bequem von zu Hause aus Fachwissen in diesem ständig wachsenden Bereich anzueignen. Bereiten Sie sich darauf vor, ein Experte für die hochwertige medizinische Versorgung von Reisenden und die Förderung der globalen Gesundheit zu werden. An der TECH Technologischen Universität liegt uns die Gesundheit und das Wohlbefinden von Menschen auf der ganzen Welt am Herzen. Mit unserem Kurs tauchen Sie in die interessante Welt der Reisemedizin und des internationalen Gesundheitswesens ein und erlernen die Grundlagen, um die spezifischen medizinischen Herausforderungen von Reisenden und internationalen Gemeinschaften zu bewältigen. Online-Kurse sind die bequemste und flexibelste Art zu studieren. Sie können jederzeit und von jedem Ort aus auf die Kursinhalte zugreifen und Ihren Lernplan an Ihre persönlichen und beruflichen Bedürfnisse anpassen.
Spezialisieren Sie sich auf internationale Gesundheit und Reisemedizin
Im Universitätskurs in Reisemedizin und Internationale Gesundheit beschäftigen Sie sich mit Impfprotokollen und -empfehlungen, lernen tropische und im Ausland erworbene Krankheiten zu erkennen und zu behandeln und verstehen die mit internationalen Reisen verbundenen Risikofaktoren. Darüber hinaus werden Sie sich mit der Epidemiologie von Infektionskrankheiten und Präventionsstrategien zur Minimierung der weltweiten Ausbreitung von Krankheiten beschäftigen. Profitieren Sie von den Kenntnissen und der Erfahrung unserer hochqualifizierten Dozenten, die Sie durch den Kurs führen und Ihnen das nötige Rüstzeug vermitteln, um aufkommende medizinische Situationen im internationalen Umfeld zu beurteilen und zu bewältigen. Sie werden einen umfassenden Überblick über Reisemedizin und internationale Gesundheit erhalten und darauf vorbereitet sein, medizinische Herausforderungen zu meistern und die Gesundheit in einer zunehmend vernetzten Welt zu fördern. Verpassen Sie nicht die Gelegenheit, ein Experte für Reisemedizin und internationale Gesundheit zu werden! Schreiben Sie sich jetzt an der TECH Technologischen Universität ein und öffnen Sie die Türen zu einer Karriere voller Herausforderungen und Möglichkeiten im globalen Gesundheitswesen.







